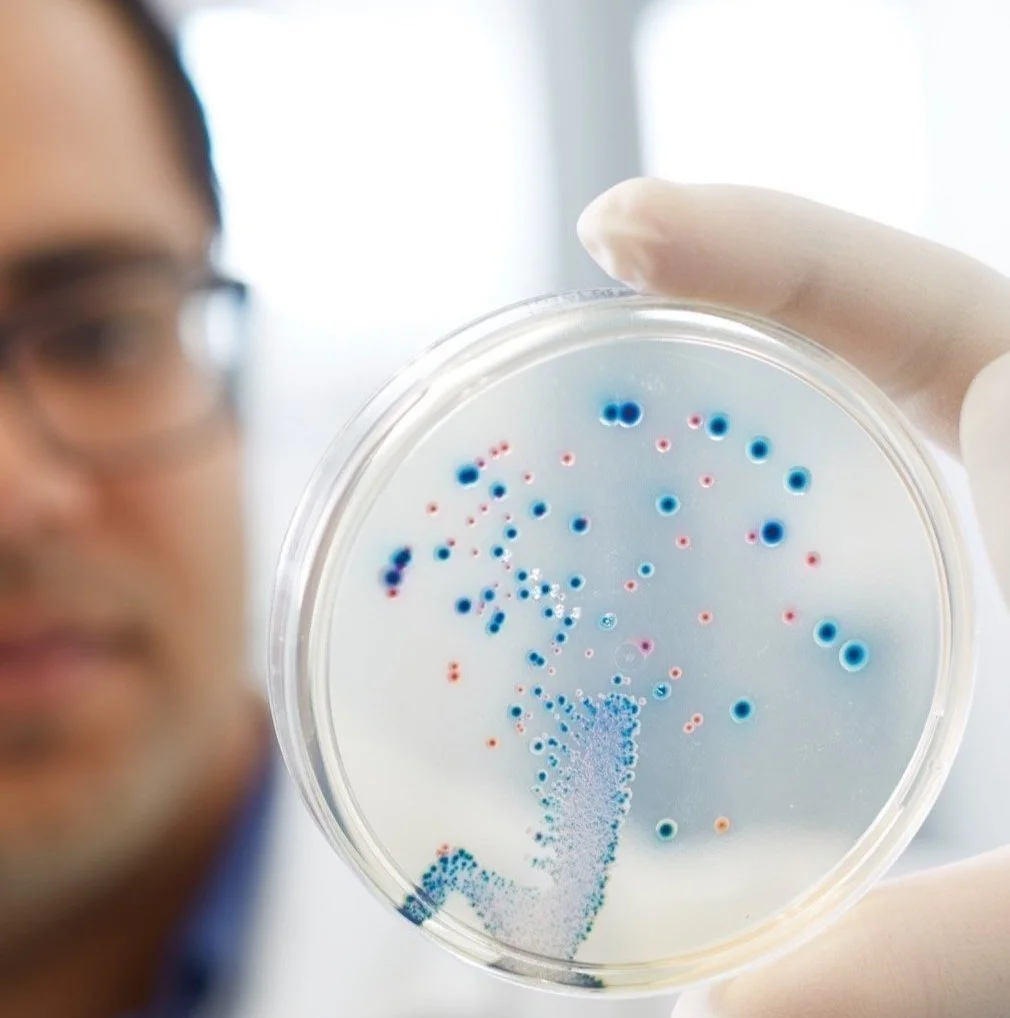
Biological20171018_1687_lores.jpg

Aquila Scientific
Your Diagnostic partner

Pioneering Innovation in Animal Health through Advanced Technology
At Aquila Scientific we aim to improve animal health through innovations in methods and approach to fill needs identified by our clients. We have a suite of cutting edge robotics platforms which increase throughput and decrease time to results. We cater for infectious diseases diagnostics including serology and microbiology.
“It's inspiring to see research translated into real-world solutions for animal and human health. Aquila Scientific is driving this vision forward, using advanced technology and automation to address infectious diseases and antimicrobial resistance. We're committed to transforming health outcomes through innovative diagnostics and high-throughput testing” - Sam Abraham (Founder and Director - Aquila Scientific)
We work with our clients to provide a service customised to their needs from outbreak diagnostics to routine serology. Contact us today to see how we can work with you to provide services in microbiology and infectious diseases.
Services
Get in Touch
Contact Aquila Scientific today to see how we can assist you in the detection of infectious diseases.